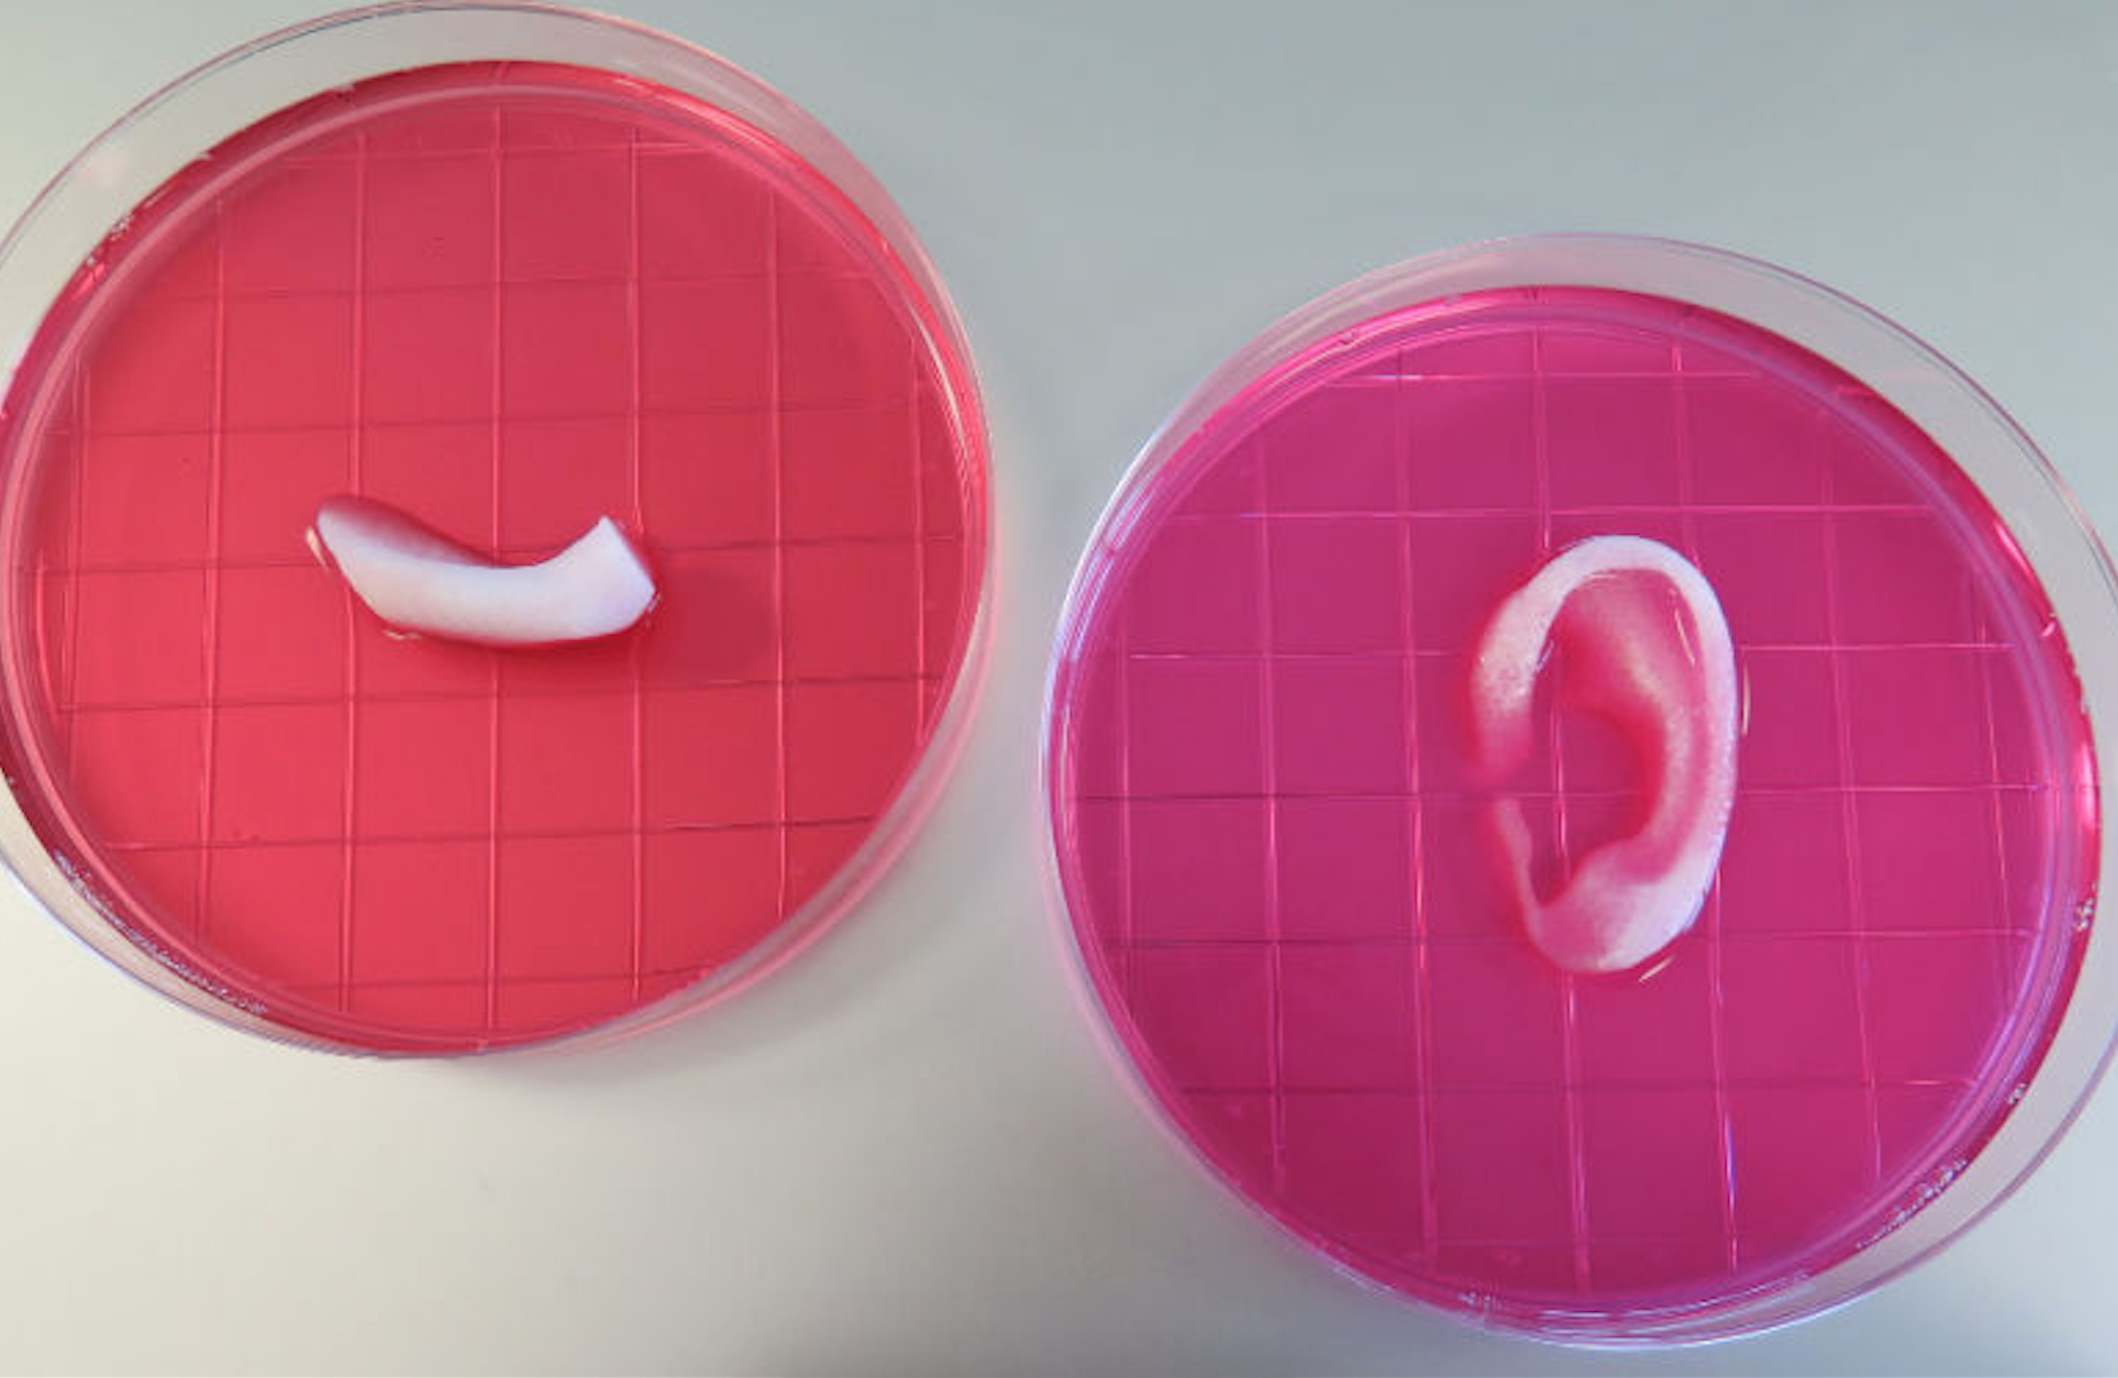
A New Type of 3D Printers Could Be the Future of Prosthetics

A team comprised of biomedical researchers at Wake Forest Institute for Regenerative Medicine gave news that a new type of 3D printers could be the future of prosthetics. And the reason they did that was because they just managed to successfully complete a device that took 10 years to develop; one that can print different types of tissue such as bone, cartilage and muscle.
This invention is capable of turning simple tissues into large and complex shapes such as human ears. But they are more than just simple prosthetics as they are, for the lack of a better word, alive. They consist of real, evolving and natural human cells that don’t act only as a filler. Initial experiments of printing things such as growing muscle or small bones, which later got implanted into animals showed that these 3D tissue prints actually survive and thrive in the host body.
While the study and development of the 3D printer used for these ‘prosthetics’ has been undergoing for years, the scientists working on it had two seemingly impossible to breach barriers. One was being able to print out bone or cartilage that wouldn’t fall apart; the other was building them in such a way that they would be accepted by a living organism, as well as function, adapt and evolve along with it.
Surprisingly though, they managed to achieve passing the second problem using a gel created from live human or animal cells as well as a biodegradable plastic called polycaprolactone. The latter is the material responsible for keeping the printed structure well bound together and sound while the growing cells start developing. With time, the plastic degrades away, leaving only alive cells – now stable and being able to remain in place by themselves – as the only material that the structure is made of.
This was the most important breakthrough of the entire development of the 3D tissue printer; by printing out the structures in an intermittent pattern, alternating the plastic gel with real tissue, the printed result can withstand the incipient phase of its life until cells begin developing and regenerating into the spaces that the degradable plastic leaves behind.
The first real experiment of a 3D printed prosthetic being implanted in a rat – in this particular case it was a strip of printed muscle – had amazing results. Not only that the muscle survived and developed into the rat’s body, but after initial lack of response to electric prodding, the muscle started to grow both blood vessels and nerves.
Future research will most likely lead to even more proficient 3D tissue printers that could aid human beings receive new body parts for implanting.
Image Source: 1









